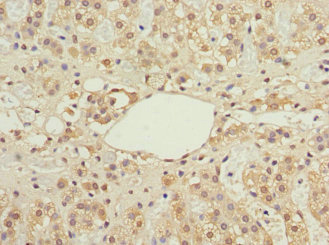

IFRD1 Antibody
-
中文名稱:IFRD1兔多克隆抗體
-
貨號:CSB-PA011069ESR2HU
-
規格:¥440
-
圖片:
-
Western blot
All lanes: IFRD1 antibody at 1.76μg/ml
Lane 1: Mouse skeletal muscle tissue
Lane 2: Hela whole cell lysate
Lane 3: Jurkat whole cell lysate
Secondary
Goat polyclonal to rabbit IgG at 1/10000 dilution
Predicted band size: 51, 46 kDa
Observed band size: 51 kDa -
Immunohistochemistry of paraffin-embedded human brain tissue using CSB-PA011069ESR2HU at dilution of 1:100
-
Immunohistochemistry of paraffin-embedded human adrenal gland tissue using CSB-PA011069ESR2HU at dilution of 1:100
-
-
其他:
產品詳情
-
產品描述:
The recombinant human IFRD1 protein (1-240aa) was used as an immunogen to elicit an immune response in rabbits. Once the immune response was generated, the rabbit serum was collected and subjected to antibody purification using antigen affinity purification.
The purified rabbit anti-human IFRD1 polyclonal antibody is then characterized by various assays including ELISA, WB, and IHC to confirm its specificity and sensitivity. This IFRD1 antibody can detect human and mouse IFRD1 proteins. The target protein IFRD1 mainly functions to regulate cell growth, differentiation, and apoptosis. It is also involved in various cellular processes, including cell cycle progression, DNA repair, and immune response.
-
產品名稱:Rabbit anti-Homo sapiens (Human) IFRD1 Polyclonal antibody
-
Uniprot No.:
-
基因名:IFRD1
-
別名:12 O tetradecanoylphorbol 13 acetate induced sequence 7 antibody; IFRD1 antibody; IFRD1_HUMAN antibody; interferon related developmental regulator 1 antibody; Interferon-related developmental regulator 1 antibody; Nerve growth factor inducible protein PC4 antibody; Nerve growth factor-inducible protein PC4 antibody; PC4 antibody; Pheochromocytoma cell 4 antibody; TIS7 antibody; TPA induced sequence 7 antibody
-
宿主:Rabbit
-
反應種屬:Human, Mouse
-
免疫原:Recombinant Human Interferon-related developmental regulator 1 protein (1-240AA)
-
免疫原種屬:Homo sapiens (Human)
-
標記方式:Non-conjugated
-
克隆類型:Polyclonal
-
抗體亞型:IgG
-
純化方式:Antigen Affinity Purified
-
濃度:It differs from different batches. Please contact us to confirm it.
-
保存緩沖液:PBS with 0.02% sodium azide, 50% glycerol, pH7.3.
-
產品提供形式:Liquid
-
應用范圍:ELISA, WB, IHC
-
推薦稀釋比:
Application Recommended Dilution WB 1:1000-1:5000 IHC 1:20-1:200 -
Protocols:
-
儲存條件:Upon receipt, store at -20°C or -80°C. Avoid repeated freeze.
-
貨期:Basically, we can dispatch the products out in 1-3 working days after receiving your orders. Delivery time maybe differs from different purchasing way or location, please kindly consult your local distributors for specific delivery time.
-
用途:For Research Use Only. Not for use in diagnostic or therapeutic procedures.
相關產品
靶點詳情
-
功能:Could play a role in regulating gene activity in the proliferative and/or differentiative pathways induced by NGF. May be an autocrine factor that attenuates or amplifies the initial ligand-induced signal.
-
基因功能參考文獻:
- Results from a study on gene expression variability markers in early-stage human embryos shows that IFRD1 is a putative marker for the 3-day, 8-cell embryo stage. PMID: 26288249
- High IFRD1 colon cancer expression was significantly associated with decreased 5-year patient survival. PMID: 29094309
- this study shows that IFRD1 gene may be associated with pathogenesis of asthma PMID: 27842724
- rs7817 polymorphism associated with nasal polyposis in cystic fibrosis patients PMID: 26397160
- study reveals an EGFR-IFRD1-mediated viral immune evasion mechanism, which can also be exploited by cancer cells PMID: 26055519
- rs5009270 may contribute to hip OA susceptibility by altering proximal femur shape. PMID: 25939412
- PC4 plays essential roles in the transition step from transcription initiation to elongation by binding to melted DNA in collaboration with TFIIEbeta. PMID: 25308091
- Studied the association between IFRD1 polymorphisms and gastric cancer in a Chinese population. PMID: 25073439
- IFRD1 expression is systemically up-regulated in CF neutrophils, is linked to the production of ROS, and is modulated by chemokines in CF airway fluids, depending on the IFRD1 genotype. PMID: 23043087
- This work provides evidence for the first time of reduced level of IFRD1 protein in murine and human F508del-CFTR airway epithelial cell models. PMID: 21723850
- IFRD1 is a target gene of the BACH1 transcription factor according to ChIP-seq analysis in HEK 293 cells. PMID: 21555518
- This reference shows the cloning and the sequence of the original IFRD1 homolog isolated in rat as nerve growth factor-inducible immediate early gene (named PC4). PMID: 2467301
- IFRD1 is an inducer of skeletal muscle regeneration and of satellite cell amplification, by regulating MyoD and NF-kB. PMID: 21127072
- Identification of PC4/IFRD1 as a coactivator of MyoD, a key master gene of muscle development. PMID: 15743821
- In the absence of PC4/IFRD1 skeletal muscle differentiation is defective. PMID: 7756174
- IFRD1 mRNA decay stress-sensitive regulation is mediated by an upstream open reading frame PMID: 20080976
- TIS7, a negative regulator of transcriptional activity, represses expression of OPN and beta-catenin/Tcf-4 target genes PMID: 16204248
- identification of IFRD1 as a modifier of cystic fibrosis lung disease severity PMID: 19242412
- Sequence conservation, animal models, and protein structure evaluation support the involvement of IFRD1 in SMNA PMID: 19409521
- This reference shows the cloning and the sequence of the original IFRD1 homolog isolated in mouse as TPA-inducible immediate early gene (named Tis7). PMID: 2797820
- Identification of the IFRD gene family, comprising the two genes PC4 / Tis7 / IFRD1 and SKMc15 / IFRD2, and in situ-hybridization analysis of their expression during developments PMID: 9722946
- PC4/IFRD1 is able to potentiate the transcription of many genes and to inhibit the transcription of few others, thus acting as regulator of transcription, possibly involved in tissue regeneration PMID: 12691737
- Functional ablation of PC4/IFRD1 in myoblast cells by sense and antisense strategies as well as by microinjection of PC4/IFRD1 antibodies, inhibits differentiation. PMID: 7756174
- PC4/IFRD1, known to be required for muscle differentiation, coactivates MyoD by relieving the HDAC4-mediated inhibition of MEF2C, as a result of its ability to dose-dependently displace HDAC4 from MEF2C. PMID: 15743821
- This reference (Tirone and Shooter 1989) shows the cloning and the sequence of the original IFRD1 homolog, isolated in rat as NGF-inducible immediate early gene (named PC4). PMID: 2467301
顯示更多
收起更多
-
蛋白家族:IFRD family
-
組織特異性:Expressed in a variety of tissues.
-
數據庫鏈接:
Most popular with customers
-
-
YWHAB Recombinant Monoclonal Antibody
Applications: ELISA, WB, IHC, IF, FC
Species Reactivity: Human, Mouse, Rat
-
-
-
-
-
-